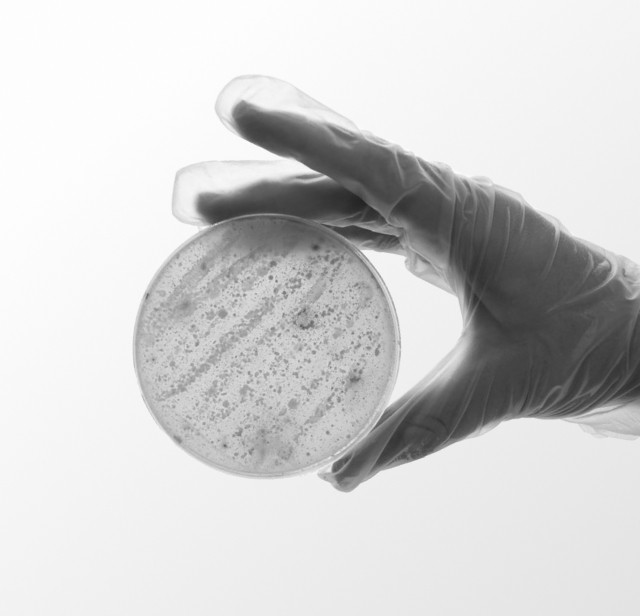
Рука держит образец с анализом

Экспресс сервис доставки реактивов и полимеров
Доставка из любой точки мира для лабораторий и производств по всей России
Быстрые поставки
Доставим заказ в течение 3 недель
Сертифицированные товары
Только качественная продукция
Удобный заказ
Выбирайте в онлайн-каталоге
Популярные позиции в каталоге
CellTrace™ Violet Cell Proliferation Kit, for flow cytometry
Производитель
Thermo Fisher
Фасовка
180 assays
CAS
—
Артикул
C34557
98 610 ₽
Cellulose Acetate Membrane Filters Discs/ Type 11106, pore size 0.45 µm, 100 pieces per pack
Производитель
Sartorius
Фасовка
100 pieces
CAS
—
Артикул
11106--50------N
38 400 ₽
Dextran from Leuconostoc spp.
Производитель
Sigma-Aldrich
Фасовка
25G
CAS
9004-54-0
Артикул
31390-25G
27 420 ₽
Alexa Fluor® 647 anti-Tyrosine Hydroxylase Antibody
Производитель
Biolegend
Фасовка
25 µg
CAS
—
Артикул
818007
58 200 ₽
Levofloxacin
Производитель
Sigma-Aldrich
Фасовка
1G
CAS
100986-85-4
Артикул
28266-1G-F
12 980 ₽
BD Pharmingen™ PE Mouse Anti-Human CD4 100 tests
Производитель
BD
Фасовка
100 tests
CAS
—
Артикул
566679
29 250 ₽
TEV Protease, 1000U
Производитель
ApexBio
Фасовка
1000U
CAS
—
Артикул
К1098
19 740 ₽
Invitrogen, GFAP Monoclonal Antibody (GA5), eBioscience™
Производитель
Thermo Fisher
Фасовка
25 µg
CAS
—
Артикул
14-9892-80
48 590 ₽
S817632 Sodium 1-hexanesulfonate,98%
Производитель
Macklin
Фасовка
100g
CAS
2832-45-3
Артикул
S817632-100g
15 680 ₽
Упаковка из 5 шт., гребни для электрофорезной ячейки Mini-PROTEAN, используются со стеклянными пластинами диаметром 1,0 мм (1653311)
Производитель
Bio-Rad
Фасовка
5 шт/уп.
CAS
—
Артикул
1653360
17 630 ₽
Продукция
Реактивы и стандарты
Лабораторное оборудование
Диагностические системы и наборы
Посуда и расходные материалы
Хроматографические колонки
Малотоннажная химия и сырьё
Полимеры и наноматериалы
Микробиология
Прозрачная логистика
Вы в любой момент времени будете знать, где находится ваш заказ
1
Любой объём заказа
Доставляем продукцию небольшим лабораториям и крупным производствам
2
Температурный режим
Соблюдаем рекомендуемые температурные режимы на всех этапах доставки
3
Минимальная наценка
Работаем напрямую с производителями без лишних посредников
Наши поставщики уже готовы отгрузить ваш заказ
В нашем каталоге есть продукция более чем 50 производителей из США, Европы и Азии. Если вам нужно что‑то, чего пока нет в нашем каталоге, то оставьте заявку — мы найдём и доставим это

Азия

Arista Biologicals

Cayman Chemical

CD

Cusabio

FineTest

Genolution

GenScript

LeapChem

Macklin

Nest

Pharmaffiliates

Servicebio

Sino Biological

SnapGene

Solarbio

TianGen

Trajan

Tran

Tribi Science

Vazyme
Европа и Америка

ATCC

BD

BioLegend

BioRad

Carlo Erba

Cell Biolabs

Corning

Chromogenix

Greiner Bio-One

LGC

LSBio

Merck (Sigma)

Milteniy Biotec

PanReac AppliChem

Phenomenex

Promega

Qiagen

Sartorius

TaKaRa

TCI

Thermo Fisher

USP

Waters
Доставка
Если продукция нужна срочно, воспользуйтесь экспресс-доставкой и максимум через 3 недели заказ будет у вас
Вы подбираете позиции в каталоге и оформляете заказ
В течение 24 часов отправляем коммерческое предложение вам на почту
Обсуждаем условия поставки, сроки и подписываем договор
Подтверждаем заказ, готовим к отгрузке, передаём в доставку
В любой момент вы можете проверить, где находится ваш заказ
Инфраструктура
офисы Реакто
офисы партнёров

Надоело спускать огромные бюджеты на реактивы?
Мы поможем обеспечить вашу лабораторию или производство всем необходимым, сэкономим ваш бюджет и доставим всё точно в срок
Или отправьте заявку на нашу почту

Вопрос-ответ
Заявка на доставку
Оставьте свои контактные данные, добавьте список позиций для заказа или прикрепите файл